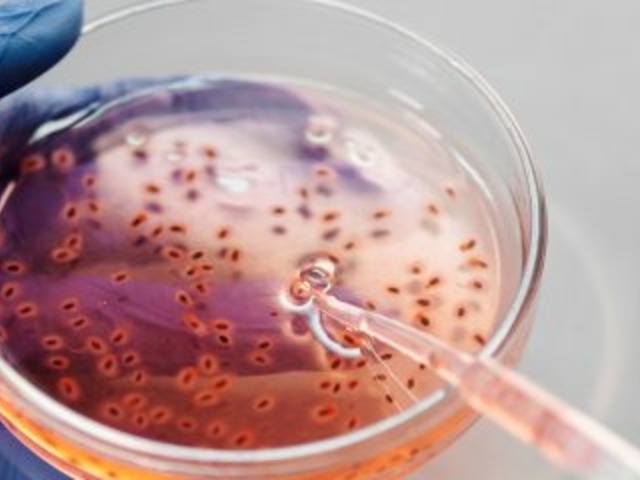

Empresa brasileira cria teste para descobrir nossa idade biológica
Mega Curioso
Quando falamos sobre idade, a maioria de nós pensa no tempo cronológico, isto é, nos dias e anos que se passaram desde o nosso nascimento. No entanto, temos outra idade, a biológica, que pode ser maior ou menor do que aquela confirmada pela nossa certidão de nascimento.
 (Fonte: Andrea Piacquadio / Pexels/ Reprodução)
(Fonte: Andrea Piacquadio / Pexels/ Reprodução)
Seguindo por esse caminho, a empresa brasileira de biotecnologia Biological Age anunciou recentemente mais uma inovação: um teste que pode ajudar a detectar sua idade biológica. Mas por que isso é importante?
Idade biológica vs. idade cronológica
A ferramenta, batizada de BioAgeTeste, faz a análise do DNA da pessoa por meio de uma amostra de seu sangue. No caso dessa novidade brasileira, a medição da idade biológica é feita a partir dos telômeros, nucleotídeos situados nas extremidades dos cromossomos.
 (Fonte: Polina Tankilevitch / Pexels/ Reprodução)
(Fonte: Polina Tankilevitch / Pexels/ Reprodução)
Para fazer a conta, o BioAgeTeste toma como base um número de referência a partir do qual compara o comprimento dos telômeros de seu DNA. E, assim, a sua idade biológica é definida. Por isso, como seres humanos, podemos dizer que temos duas idades diferentes: a cronológica e a biológica. A primeira diz respeito ao tempo real de vida de uma pessoa, ou seja, o número de dias, meses ou anos que ela está viva. Já a segunda se refere à idade que uma pessoa "parece", isso significa que você pode ter 30 anos, mas seu organismo apontar ter mais ou menos do que isso.
Segundo a empresa desenvolvedora do teste, o ideal é que a idade biológica seja sempre menor do que a idade cronológica. Contudo, caso seja maior, existe a possibilidade de reverter o envelhecimento celular.
A idade biológica considera uma série de fatores externos, como a dieta alimentar, o estilo de vida, hábitos de sono ou se você prática exercícios físicos, apenas para citar alguns, ou seja, é influenciada por muito mais aspectos do que somente a quantidade de dias que se passaram desde o seu nascimento.
 (Fonte: Andrea Piacquadio / Pexels/ Reprodução)
(Fonte: Andrea Piacquadio / Pexels/ Reprodução)
Já faz algum tempo que cientistas têm estudado esse assunto. Atualmente, as pesquisas mais avançadas de medições da idade biológica envolvem os telômeros. Fundamentalmente, eles são responsáveis por determinar a rapidez com que as células envelhecem e morrem.
A cada divisão celular, um telômero se encurta e, quando esse nucleotídeo está curto demais, ele não consegue proteger a célula como deveria, o que faz ela se tornar disfuncional. Aliás, a ciência já sabe que, quanto mais curtos são os telômeros de uma pessoa, mais propensa ela é de desenvolver doenças e distúrbios neurodegenerativos ou de morrer precocemente.


